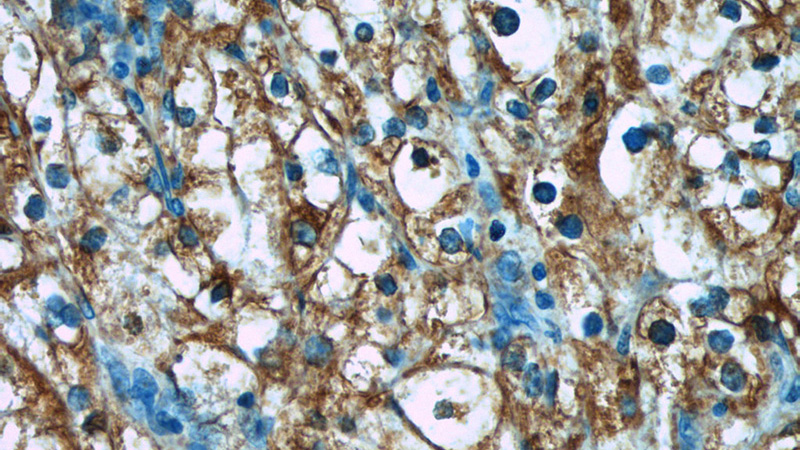
Immunohistochemistry of paraffin-embedded human renal cell carcinoma tissue slide using Catalog No:117200(BMP7 Antibody) at dilution of 1:50 (under 40x lens)

-
Product Name
BMP7 antibody
- Documents
-
Description
BMP7 Rabbit Polyclonal antibody. Positive IP detected in HEK-293 cells. Positive WB detected in HEK-293 cells, MCF7 cells. Positive IF detected in HeLa cells. Positive IHC detected in human renal cell carcinoma tissue, human bladder tissue, human kidney tissue. Observed molecular weight by Western-blot: 49 kDa
-
Tested applications
ELISA, IHC, WB, IP, IF
-
Species reactivity
Human,Mouse,Rat; other species not tested.
-
Alternative names
BMP 7 antibody; BMP7 antibody; bone morphogenetic protein 7 antibody; Eptotermin alfa antibody; OP 1 antibody; OP1 antibody; Osteogenic protein 1 antibody
-
Isotype
Rabbit IgG
-
Preparation
This antibody was obtained by immunization of BMP7 recombinant protein (Accession Number: NM_001719). Purification method: Antigen affinity purified.
-
Clonality
Polyclonal
-
Formulation
PBS with 0.1% sodium azide and 50% glycerol pH 7.3.
-
Storage instructions
Store at -20℃. DO NOT ALIQUOT
-
Applications
Recommended Dilution:
WB: 1:500-1:5000
IP: 1:200-1:2000
IHC: 1:20-1:200
IF: 1:20-1:200
-
Validations

HEK-293 cells were subjected to SDS PAGE followed by western blot with Catalog No:117200(BMP7 Antibody) at dilution of 1:1000

IP Result of anti-BMP7 (IP:Catalog No:117200, 4ug; Detection:Catalog No:117200 1:800) with HEK-293 cells lysate 2800ug.

Immunohistochemistry of paraffin-embedded human renal cell carcinoma tissue slide using Catalog No:117200(BMP7 Antibody) at dilution of 1:50 (under 10x lens)
Immunohistochemistry of paraffin-embedded human renal cell carcinoma tissue slide using Catalog No:117200(BMP7 Antibody) at dilution of 1:50 (under 40x lens)

Immunofluorescent analysis of HeLa cells using Catalog No:117200(BMP7 Antibody) at dilution of 1:50 and Alexa Fluor 488-congugated AffiniPure Goat Anti-Rabbit IgG(H+L)
-
Background
The bone morphogenetic proteins (BMPs) are a family of secreted signaling molecules that can induce ectopic bone growth. Many BMPs are part of the transforming growth factor-beta (TGFB) superfamily. BMPs were originally identified by an ability of demineralized bone extract to induce endochondral osteogenesis in vivo in an extraskeletal site. BMP7, also known as osteogenic protein-1 or OP-1, plays a key role in the transformation of mesenchymal cells into bone and cartilage. BMP7 may be involved in bone homeostasis (PMID: 15621726). It is expressed in the brain, kidneys and bladder. BMP7 is also present in cancers, including breast, prostate, and colon cancers, in which it is implicated in regulating cancer cell proliferation (PMID: 16419056, PMID: 15531927). Overexpression of BMP7 mRNA in colorectal cancer patients was significantly associated with poor prognosis and low overall survival (PMID: 18259822). Recent studies suggest that high-expression level of BMP7 serves as a biomarker for poor prognosis for HCC (PMID: 23179403).
-
References
- Li W, Cai HX, Ge XM, Li K, Xu WD, Shi WH. Prognostic significance of BMP7 as an oncogene in hepatocellular carcinoma. Tumour biology : the journal of the International Society for Oncodevelopmental Biology and Medicine. 34(2):669-74. 2013.
- Liu Z, Zhou Y, Yuan Y. MiR542-3p Regulates the Epithelial-Mesenchymal Transition by Directly Targeting BMP7 in NRK52e. International journal of molecular sciences. 16(11):27945-55. 2015.
Related Products / Services
Please note: All products are "FOR RESEARCH USE ONLY AND ARE NOT INTENDED FOR DIAGNOSTIC OR THERAPEUTIC USE"
